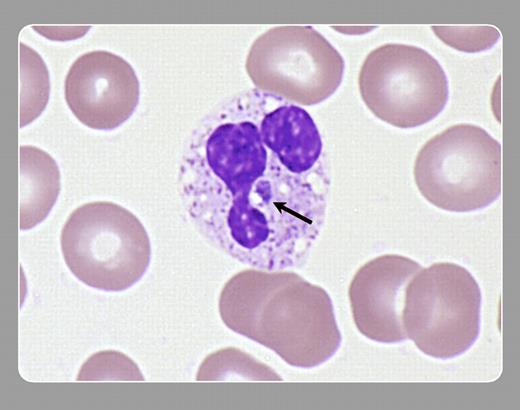
Peter Maslak and Lisa Southern, Memorial Sloan-Kettering Cancer Center

Topics:
ehrlichiosis
Peter Maslak and Lisa Southern, Memorial Sloan-Kettering Cancer Center
Peter Maslak and Lisa Southern, Memorial Sloan-Kettering Cancer Center
Ehrlichia are intracellular gram negative bacteria that can be transmitted by ticks to humans from dogs, deer, or horses. The organisms appear as a clusterlike inclusion (or morula; see arrow) within vacuoles of the host granulocytes.FIG1
Copyright © 2003 by The American Society of Hematology
2003
This feature is available to Subscribers Only
Sign In or Create an Account Close Modal